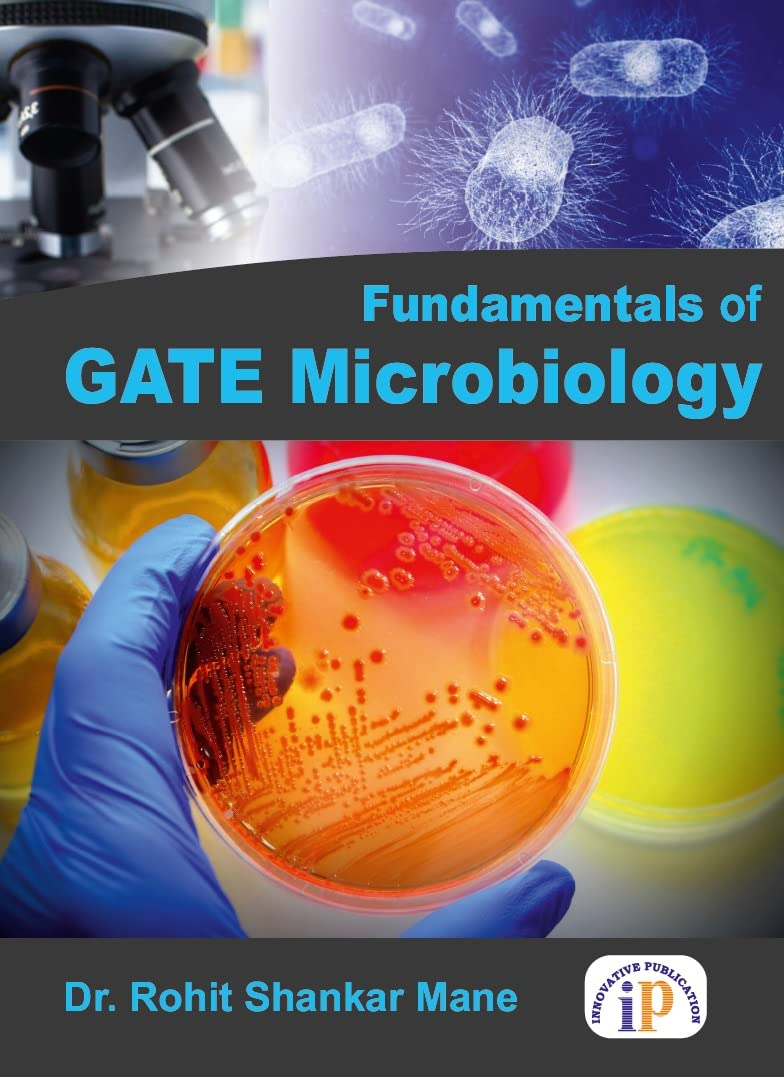
Fundamentals of GATE Microbiology

-
Home
-
Subjects
- Administration & Management
- Allergy & Infectious Diseases
- Anaesthesia
- Anatomy
- Anatomy and Physiology
- Assessment & Diagnosis
- Basic Science
- Behavioral Science
- Biochemistry
- Biochemistry For Nurses
- Biomedical science
- Biophysics
- Biostatistics
- Cardiology
- Care Planning
- Cell Biology
- Communication and Educational Technology
- Community Dentistry
- Community Health Nursing
- Community Medicine
- Complementary Medicine
- Conservative Dentistry
- Critical Care
- Crown and Bridge
- Cytology
- Dental Materials
- Dermatology / Skin
- Diabities
- Dictionary
- Dietetics
- Embryology
- Emergency Medicine
- Endocrinology
- Endodontics
- Epidemiology
- First Aid
- Forensic Medicine and Toxicology
- Forensic Nursing
- Fundamentals and Foundations of Nursing
- Gastroenterology
- General English
- Genetrics
- Geriatric & Family Medicine
- Gerontology
- Gynaecology
- Haematology
- Hepatology
- Histology
- Hospital Management / Medical Education
- Immunology
- Infectious Disease
- Instruments
- Internship
- Leprosy
- Medical Laboratory Technology
- Medical Statistics
- Medical Surgical Nursing
- Medicine
- Microbiology
- Midwifery
- Molecular Biology
- MRCP/MRCS/MFDS
- NCLEX
- Nephrology
- Neuroanatomy
- Neurology & Neurosurgery
- Nurse Assisting
- Nursing Education
- Nursing Informatics and Technology
- Nursing Management & Services
- Nursing Management and Leadership
- Nursing Research and Statistics
- Nutrition
- Obstetrics
- Oncology
- Ophthalmology
- Oral And Maxillofacial Surgery
- Oral Histology
- Oral Medicine And Radiology
- Oral Microbiology
- Oral Pathology
- Orthodontics
- Orthopaedics
- Osteology
- Others
- Otolaryngology (ENT)
- Paediatric & Preventive Dentistry
- Pain Medicine
- Palliative Medicine
- Parasitology
- Pathology
- Pathology & Genetics
- Pediatric Nursing
- Pediatrics
- Periodontology
- PGDEE
- PGMEE
- Pharmacology
- Physical Medicine &,Rehabilitation
- Physiology
- PLAB
- Plastic Surgery
- Preventive and Social Medicine
- Prosthodontics
- Psychiatric and Mental Health Nursing
- Psychiatry
- Psychology
- Public Health Dentistry
- Pulmonary Medicine / Respiratory Medicine
- Radiology
- Rheumatology
- Sleep Medicine
- Sociology
- Sports Medicine
- Staff Nurse Entrance / Nursing Competition Exams
- Super Speciality
- Surgery
- Therapeutics
- Tumours
- UG Exam Books / MCQs / Viva
- Urology
- USMLE
- Vascular Surgery
- Physiotherapy
- Pharmacy
- Homeopathy
- Implantology
- FMGE
- Ayurveda
- General Practice/Physician
- Veterinary
- A.N.M- Auxiliary Nursing Midwifery
- G.N.M-General Nursing and Midwifery
- GMAT/GRE
- NEET UG PREP
- Orthopedics
- Hematology
- Obstetrics & Gynecology
- Internal Medicine
- Adult Health (Medical Surgical) Nursing
- Oral Maxillofacial Surgery
- Clinical Lab Sciences
- Anesthesia
- Chiropractic
- Physical Therapy
- Conservative Dentistry & Endodontics
- General Anatomy, Embryology & Histology
- Urology
- Oral Medicine & Radiology
- Health Education And Wellness Series
- General Surgery
- Hospital Administration
- Community, Preventive & Social Medicine
- Community, Preventive & Social Medicine
- Community, Preventive & Social Medicine/Nursing Research & Statistics
- Otolaryngology/Smart Study Series
- General Pathology & Microbiology
- General Medicine
- Child Health Nursing
- Midwifery / Obstetrics & Gynecology (OBG) Nursing
- Nursing Management & Leadership
- Orthopedics/ Internal Medicine
- Chaitow
- Cam & Massage
- Neurology
- Medicine
- Medicine
- Medical Teaching
- Competitive Examination
- Applied Psychology
- Anatomy & Physiology
- Oral Pathology & Oral Microbiology
- Radiology/ Imaging technology
- Professionalism, values & Bioethics
- Pediatrics
- Nursing Foundation
- Ophthalmology/ Optometry
- Clinical Lab Sciences
- Respiratory Care
- Pathology
- Internal Medicine, Pediatrics
- Oral Anatomy, Embryology & Histology
- Medical Science
- Cardiology / Nuclear Medicine
- Head and Neck Surgery
- Surgery / Cartilage Repair
- Orthopedic Trauma / Medicolegal Reporting
- Hematology / Stem Cell Transplantation
- Pediatric Palliative Care
- Emergency Medicine / Radiology
- Optics / Optical Science
- Oncology / Hematopathology
- Cardiothoracic Surgery
- Hand Surgery / Orthopedics
- Orthopedics / Sports Medicine
- Orthopedics / Sports Medicine
- Emergency Medicine / Orthopedics
- Internal Medicine
- Information Technology {IT}
-
Booktype
-
MBBS
-
BDS
-
Nursing
-
Exclusive
-
Oxford Medi. Handbooks
-
WHO Series
-
Ayurveda
-
General Books
- Art/Architecture/History
- Astrology
- Autobiographies And Biographies
- Automobile Engineering
- Biography/Leadership
- Bioinformatics
- Biotechnology
- Business
- Career
- Change Management
- Children?s Books
- Civil Engineering
- Communication
- Communication/Reference
- Banking Computer Science
- Cookery
- Corporate Governance
- Creativity
- Current Affairss
- Economics
- Electronic Commerce
- Engineering Mathematics
- Entrepreneurship
- Environmental Management
- Environmental Technology & Management
- Ethics
- Family Businesse
- Fiction
- Finance
- Games & Puzzles
- General Management
- General Reference
- Health/Memoiru
- History
- Hospitality & Tourism
- Human Resource Management
- Humour
- International Business
- Karma & Reincarnation
- Law
- Library Science
- Management Control Systems
- Management Information Systems
- Management Skillsn
- Marketing
- Mass Media
- Mechanical Engineering
- Meditation/Spirituality
- Mind, Body & Spiritri
- Motivation/Self-Help
- Nanotechnology
- Numerology
- Occult/Spirituality
- Outsourcing & Offshoring
- Palmistryr
- Parapsychology
- Parenting
- Personality Development
- Philosophy/Biography
- Poetry
- Political Science
- Popular Science
- PR & Advertising
- Pregnancy & Baby Care
- Production & Operations Management
- Production Engineering
- Project Management
- Quality Management
- Quotes On Management
- Reference
- Economic Relationships
- Religion
- Risk Management
- Sales
- Science
- Self-Help
- Sex, Marriage & Love
- Short Fiction
- Social/Political Science
- Sport/Biography
- Sports
- Strategy
- Supply Chain Management
- Test Prepb
- Time Management
- Travel
- All Others
-
Elsevier 1st Year Titles
Filters
Filters
- Administration & Management
- Allergy & Infectious Diseases
- Anaesthesia
- Anatomy
- Anatomy and Physiology
- Assessment & Diagnosis
- Basic Science
- Behavioral Science
- Biochemistry
- Biochemistry For Nurses
- Biomedical science
- Biophysics
- Biostatistics
- Cardiology
- Care Planning
- Cell Biology
- Communication and Educational Technology
- Community Dentistry
- Community Health Nursing
- Community Medicine
- Complementary Medicine
- Conservative Dentistry
- Critical Care
- Crown and Bridge
- Cytology
- Dental Materials
- Dermatology / Skin
- Diabities
- Dictionary
- Dietetics
- Embryology
- Emergency Medicine
- Endocrinology
- Endodontics
- Epidemiology
- First Aid
- Forensic Medicine and Toxicology
- Forensic Nursing
- Fundamentals and Foundations of Nursing
- Gastroenterology
- General English
- Genetrics
- Geriatric & Family Medicine
- Gerontology
- Gynaecology
- Haematology
- Hepatology
- Histology
- Hospital Management / Medical Education
- Immunology
- Infectious Disease
- Instruments
- Leprosy
- Medical Laboratory Technology
- Medical Statistics
- Medical Surgical Nursing
- Medicine
- Microbiology
- Midwifery
- Molecular Biology
- MRCP/MRCS/MFDS
- NCLEX
- Nephrology
- Neuroanatomy
- Neurology & Neurosurgery
- Nurse Assisting
- Nursing Education
- Nursing Informatics and Technology
- Nursing Management & Services
- Nursing Management and Leadership
- Nursing Research and Statistics
- Nutrition
- Obstetrics
- Oncology
- Ophthalmology
- Oral And Maxillofacial Surgery
- Oral Histology
- Oral Medicine And Radiology
- Oral Microbiology
- Oral Pathology
- Orthodontics
- Orthopaedics
- Osteology
- Others
- Otolaryngology (ENT)
- Paediatric & Preventive Dentistry
- Pain Medicine
- Palliative Medicine
- Parasitology
- Pathology
- Pathology & Genetics
- Pediatric Nursing
- Pediatrics
- Periodontology
- PGDEE
- PGMEE
- Pharmacology
- Physical Medicine &,Rehabilitation
- Physiology
- PLAB
- Plastic Surgery
- Preventive and Social Medicine
- Prosthodontics
- Psychiatric and Mental Health Nursing
- Psychiatry
- Psychology
- Public Health Dentistry
- Pulmonary Medicine / Respiratory Medicine
- Radiology
- Sociology
- Sports Medicine
- Staff Nurse Entrance / Nursing Competition Exams
- Super Speciality
- Surgery
- Therapeutics
- Tumours
- UG Exam Books / MCQs / Viva
- Urology
- USMLE
- Vascular Surgery
- Physiotherapy
- Pharmacy
- Homeopathy
- Implantology
- FMGE
- Ayurveda
- General Practice/Physician
- Veterinary
- A.N.M- Auxiliary Nursing Midwifery
- G.N.M-General Nursing and Midwifery
- GMAT/GRE
- NEET UG PREP
- Orthopedics
- Hematology
- Obstetrics & Gynecology
- Internal Medicine
- Adult Health (Medical Surgical) Nursing
- Oral Maxillofacial Surgery
- Clinical Lab Sciences
- Anesthesia
- Chiropractic
- Physical Therapy
- Conservative Dentistry & Endodontics
- General Anatomy, Embryology & Histology
- Urology
- Oral Medicine & Radiology
- Health Education And Wellness Series
- General Surgery
- Hospital Administration
- Community, Preventive & Social Medicine
- Community, Preventive & Social Medicine/Nursing Research & Statistics
- Otolaryngology/Smart Study Series
- General Pathology & Microbiology
- General Medicine
- Child Health Nursing
- Midwifery / Obstetrics & Gynecology (OBG) Nursing
- Nursing Management & Leadership
- Orthopedics/ Internal Medicine
- Cam & Massage
- Neurology
- Medicine
- Medical Teaching
- Competitive Examination
- Applied Psychology
- Anatomy & Physiology
- Oral Pathology & Oral Microbiology
- Radiology/ Imaging technology
- Professionalism, values & Bioethics
- Nursing Foundation
- Ophthalmology/ Optometry
- Clinical Lab Sciences
- Respiratory Care
- Pathology
- Internal Medicine, Pediatrics
- Oral Anatomy, Embryology & Histology
- Medical Science
- Cardiology / Nuclear Medicine
- Head and Neck Surgery
- Surgery / Cartilage Repair
- Orthopedic Trauma / Medicolegal Reporting
- Hematology / Stem Cell Transplantation
- Pediatric Palliative Care
- Emergency Medicine / Radiology
- Optics / Optical Science
- Oncology / Hematopathology
- Cardiothoracic Surgery
- Hand Surgery / Orthopedics
- Orthopedics / Sports Medicine
- Emergency Medicine / Orthopedics
- Information Technology {IT}
Latest Products
₹20838
₹24995
₹18267
₹21995
₹7529
₹8995
₹4779
₹5995
₹4646
₹5495
Showing 4 of 4 products